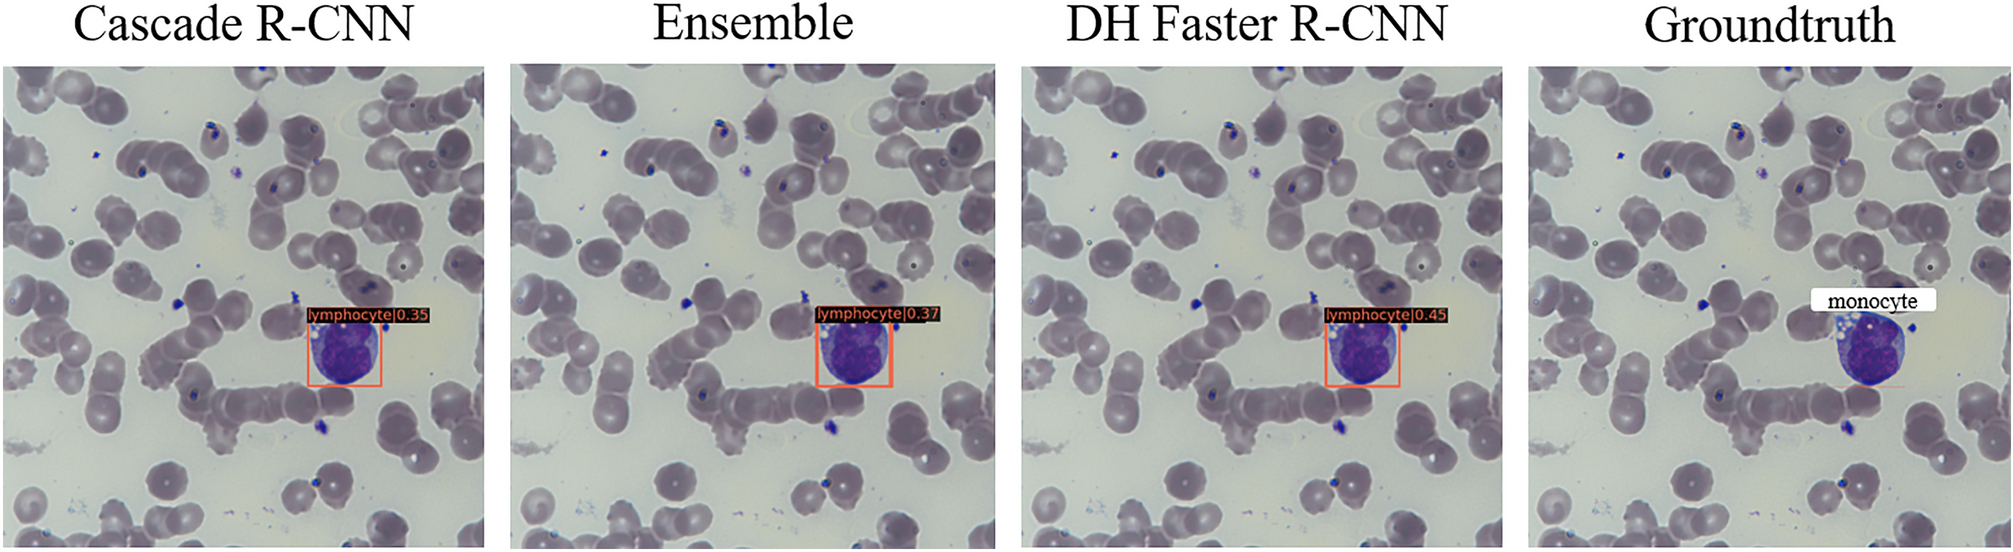
Figure 8

Figure 8
From: A deep learning model for detection of leukocytes under various interference factors
Qualitative true positive results yielded by different models. For the same leukocyte, Cascade R-CNN, Ensemble model, and DH Faster R-CNN all detect it as a lymphocyte, and experts labeled it a monocyte.